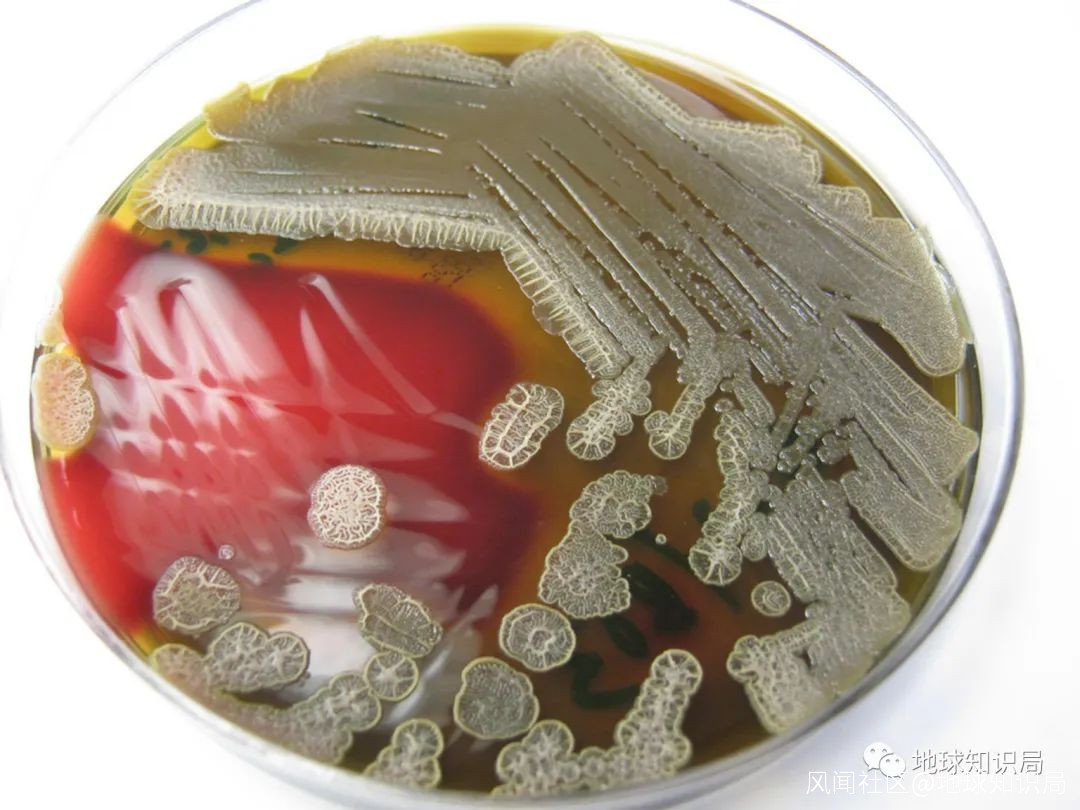

武漢突然出現的霍亂,是一種什麼病?_風聞
地球知识局-地球知识局官方账号-人文+地理+设计=全球视野新三观2022-07-15 21:21
7月9日晚,華中某高校出現一例疑似霍亂的病例,確診後整棟樓的學生都接受了肛拭子檢測。
霍亂這種似乎消失了很久的烈性傳染病重現人間,而且出現在高校這個人員聚集、流動頻繁的地方,着實讓人擔心,話題一度衝上熱搜榜第一。
霍亂是腸道傳染病,糞便中含有致病菌
想要快篩,最便捷的方法就是做肛拭子
(圖:shutterstock)▼
自1817年霍亂衝出亞洲、走向全世界開始,全球已經斷斷續續經歷了7次霍亂大流行。時至今日,人們都沒能完全消滅霍亂。
揮霍繚亂
早在《黃帝內經》中便有記載“亂於胃腸則為霍亂”,東漢末年張仲景的《傷寒論》中又有“問曰:病發熱、頭痛、身疼、惡寒、吐利者,此屬何病?答曰:此名霍亂”的記述。
然而,彼時所記載的霍亂泛指多種以腹瀉、嘔吐、發熱為表現的疾病,而非後世所特指的霍亂弧菌造成的烈性傳染病。
這種細菌,殺人無數(圖:shutterstock)▼

目前普遍認為,現代醫學所指的霍亂起源於印度恆河流域。自大航海時代開始後,前往印度的歐洲探險者多次記錄到了印度次大陸上爆發的霍亂疫情。
隨着英國人在印度的殖民活動和商貿往來
這場疫情逐漸傳播,引發了第一次霍亂大流行▼

如今,恆河的衞生狀況還是很糟糕……
(圖:shutterstock)▼

1817年,加爾各答爆發霍亂,疫情最初擴散到尼泊爾,然後向東傳播進入東南亞、印度尼西亞,而後在1820年傳入中國和日本;同時,霍亂隨着人員流動向西通過中東進入西亞和非洲;1822年前後,俄羅斯也有了霍亂的記錄。
19世紀第一次霍亂大流行,向歐亞非三個方向擴散▼

此後,霍亂就猶如一匹脱繮的野馬橫衝直撞般闖進歐洲。1831年,一艘從普魯士前往英國的船隻靠岸後,部分船員開始劇烈腹瀉,隨後迅速出現脱水的症狀,並伴有發熱、疼痛等不適,這些患者往往在幾個小時內就死去。
當地人對這種從未見過的疾病束手無策,很快全英國都籠罩在了霍亂的陰影下。疫情來襲讓居民們感覺是穿越到了1347年,運送屍體的隊伍絡繹不絕,葬禮上的鐘聲也從未斷絕。
據估計,僅1831年一年,不列顛島上就有超過3萬人死於霍亂。但瘟神並未打算停下腳步,反而跟着船隊一路向西踏上美洲大地。魁北克、紐約、費城,甚至遠在智利都有了霍亂的記錄。
細菌飄洋過海發現了新大陸,一場災難▼

智利的鄰居秘魯,也是霍亂的受害者
(霍亂防治宣傳,圖:壹圖網)▼

又是瘴氣搞的鬼?
自霍亂進入歐洲後,不到30年時間便爆發了兩次大規模疫情。回想起500年前通過隔離基本控制住了黑死病的蔓延,這次人們也有樣學樣。然而令人失望的是,就算再嚴苛的隔離,依然會有新發的霍亂病例。
時隔幾百年,瘟神再次演奏死亡樂章
(霍亂舞會,圖:wiki)▼

雖然,歐洲的醫學家已經意識到這是一種傳染病,但致病源頭究竟在哪裏卻從沒搞明白。受彼時流行的瘴氣理論影響,歐洲的醫學家們普遍認為城市惡臭的環境中產生的瘴氣便是導致疾病的罪魁禍首。
在霍亂面前人人平等,沒有高低貴賤
1836年,法國國王查理十世死於霍亂
(圖:壹圖網)▼

19世紀上半葉,英國率先完成了第一次工業革命,首都倫敦密密麻麻擠滿了新修的工廠,工廠排放的廢氣讓整個城市都瀰漫着一股詭異的味道;同時,工業化發展也讓大量人口湧入城市,但市政建設卻沒能及時跟上,城內污水橫流,到處都是一股惡臭。
在這種環境下,很難讓人不相信霍亂與惡臭環境間的密切關聯,甚至醫學權威期刊《柳葉刀》還有維多利亞女王都支持這一論點。
未知帶來恐懼,有英國人開始自制防護服
穿橡膠服,戴面罩,手持樹枝,一通搗鼓▼

1854年,正值第三次霍亂大流行時期,倫敦在這一年再次遭到了霍亂的侵襲,倫敦每天都有大量新發病例報告,但政府官員以及醫生們對於治療、預防卻毫無頭緒。
此時,英國醫生約翰·斯諾開始了一系列影響後世的研究。早在1849年,斯諾便根據自己的研究結果出版了一本名為《論霍亂的傳播方式》,其中斯諾就已經推測霍亂可能通過飲用水傳播。然而彼時瘴氣理論盛行,並沒有太多人相信斯諾的論調。
英格蘭遍地開花,倫敦是疫情高發區之一
(圖:wellcomecollection)▼

在1854年倫敦的疫情中,短短一週內便有500多人死亡,斯諾也加快了他的研究。此刻他開創性的發明了一種全新的調查方法:他將倫敦的平面地圖展開,將霍亂死亡患者的住址逐一標註,再將水井的位置標記在地圖上。
後人在斯諾原圖基礎上,加重標註的流調地圖▼

工作完成後,一切都豁然開朗:大部分病例都集中在一個位於布羅德(現在的布羅德維克)街和劍橋(現在的列剋星敦)街交匯處的西南角的水井周圍。
在斯諾苦口婆心地勸説下,市政府封閉了這口水井,此後霍亂竟真的神奇般消失了。雖然,斯諾發現了霍亂的傳播方式,但依然沒能查明致病因子,瘴氣理論依然是學界的主流觀點。
現在,布羅德維克有這口井的複製品
(圖:Flickr)▼

為了紀念這位“現代流行病學之父”
水井附近的一家酒吧以約翰·斯諾為名
(圖:wiki)▼

同樣是在1854年,意大利的幾個城鎮同樣爆發了霍亂疫情。佛羅倫薩高等研究院解剖學教授菲利波·帕西尼通過使用顯微鏡檢查死亡患者的屍體,在腸黏膜中發現了數以百萬計的逗號形狀的微生物,並明確指出是這些微生物導致了患者水和電解質的大量流失。
這種微生物是造成霍亂的元兇(圖:wiki)▼

但遺憾的是,此時微生物致病並非學界的主流觀點,人們也根本不接受帕西尼的新發現。要破除大家對瘴氣理論的迷信,還要等到十年後巴斯德的鵝頸燒瓶實驗。
1883年8月,德國科學家羅伯特·科赫(Robert Koch)前往霍亂流行的埃及亞歷山大港。在這裏,科赫和同事們從霍亂死亡患者的腸道中發現了一種其他人體內沒有的細菌。
繪製於19世紀末的霍亂患者腸道解剖圖
(圖:wellcomecollection)▼


培養皿中的霍亂弧菌,有種難以名狀的混沌感
(圖:Flickr)▼
隨後,科赫前往霍亂猖獗的印度加爾各答,在前期研究基礎上進一步在培養基中分離出了這種細菌,並描述了它的特性。雖然依然存在反對的聲音,但霍亂弧菌致病論逐漸廣泛傳播並被大家接受。
當科赫進行研究的時候,日本也在鬧霍亂
這張畫揭示了當時日本社會殘酷的一面
“霍亂怪獸”只咬生活困頓的窮苦百姓
不咬有條件去温泉療養的“上等人”▼

霍亂,又稱“虎疫”“虎列剌”“虎列拉”
傳説,日本戰國時代猛將加藤清正獵殺過老虎
日本老百姓便覺得加藤也能庇護自己不受霍亂侵害
(加藤清正的掌印,祛病消災)▼

治療霍亂
霍亂弧菌經口進入人體後,如果不能完全被胃酸以及免疫系統殺滅,就會在腸道里面大量繁殖,併產生致病性的毒素。
這些毒素可以引發腸道分泌大量液體,超過其本身的吸收能力,進而引發患者腹瀉、嘔吐。在經過及時治療後,患者通常在經過瀉吐期、脱水虛脱期以及恢復期後,才得以康復。
患者的皮膚可能會因極度缺水而變成藍灰色
因此,霍亂導致的死亡曾被稱為“藍色死亡”
(圖:wellcomecollection)▼

自1854年霍亂結束流行後,英國開始改革以往的弊端,逐步進行城市下水管網的改造,並頒佈多項法律保證城市用水質量。在多重手段綜合作用下,此後英國幾乎再沒大規模受到霍亂地襲擾。
進入20世紀後,隨着衞生條件的改善、新藥物以及疫苗的研發,霍亂的發病率以及死亡率急劇下降,大部分人都不再受到霍亂的威脅。
一戰期間,為了應對細菌武器
奧匈帝國給軍隊接種霍亂疫苗
(圖:twitter @PikeGrey1418)▼

上世紀20年代的霍亂疫苗
(圖:wellcomecollection)▼

第二次世界大戰以後,各國都開始重視衞生運動,這在一定程度上根除了霍亂髮生的土壤。新中國也幾乎消滅了困擾舊社會一百餘年的霍亂,1960年以前的十年時間裏沒有新發病例。
上世紀50年代,我國關於防治霍亂的宣傳畫
(圖:wellcomecollection)▼

自1961年後,從印度尼西亞開始爆發了世界歷史上第七次霍亂疫情,與以往不同的是,這一輪霍亂疫情的主力是埃爾託型霍亂弧菌。與之前的古典型霍亂弧菌所不同的是,埃爾託型霍亂弧菌對於環境有更強的抵抗力,同時可以造成人體溶血。
印尼人接種霍亂疫苗(圖:kompasiana)▼

自第七次霍亂大流行開始後不久,埃爾託型霍亂就迅速登陸廣東,我國也開始重新受到霍亂的襲擾。尤其是1993年,O139羣霍亂出現在中國,更是加劇了疫情防控的壓力。此後數年間,全國每年新發病例均保持在數萬例的水平。
霍亂弧菌共分為數百個血清羣
其中O1羣和O139羣可引起霍亂
而O139羣是1992年在南亞發現的新型菌株▼

進入新世紀以後,隨着對病原學以及流行病學研究的深入,各地開始實施科學精準防控,同時有賴於經濟的持續發展,霍亂在我國得到了有效控制。近幾年來,我國每年霍亂流行處於低水平位置,2021年全國新發病例僅有5例。今年在1月和3月分別有1例霍亂病例報告。
因此,雖然霍亂還沒有離我們遠去,但醫療水平的提升使霍亂早期治療後效果良好,我們完全不應過度恐慌。面對這種唯二的甲類傳染病(另一種是鼠疫),目前普遍的做法包括:
1.及時發現確診及疑似病例,並做好隔離,防止疫情擴散;
2.早期治療,快速補充因腹瀉和嘔吐丟失的水和電解質,糾正內環境紊亂,並做好抗菌、支持治療;
3.加強飲用水以及食品安全管理,對患者以及帶菌者的糞便做好消毒措施;
4.積極鍛鍊提高免疫力,疫區高危人羣接種或口服霍亂疫苗。
因為霍亂是腸道傳染病,所以也有口服疫苗
(圖:shutterstock)▼

迄今為止,我們仍處於全世界第七次霍亂流行的時代。與以往不同,全球化給多種傳染病傳播帶來了機會,新型菌株的流行也為防控帶來新的挑戰。
尤其是在部分不發達國家,由於衞生狀況較差、醫療水平不足以及居民營養不良等因素,霍亂仍然是一種較為常見的疾病。
沒有潔淨的飲用水,沒有污物處理系統
這些地方的人民就極易受到霍亂的侵害
(圖:shutterstock)▼



2020年全世界累計報告超過30萬例霍亂病例,死亡857例,但普遍認為霍亂在很大程度上被低估了(可能只有實際病例的5-10%被報告)。世界衞生組織估計,全球每年大約有300萬例新發霍亂病例,接近10萬人死亡。
因此,在抗擊霍亂的道路上,依然任重而道遠。
參考資料:
[1] 武漢大學出現一例霍亂病例!官方通報詳情. 人民融媒體. 2022-07-11 12:09發佈.
[2] Lippi D, Gotuzzo E, Caini S. Cholera. Microbiol Spectr. 2016. 4(4).
[3] Ali M, Nelson AR, Lopez AL, Sack DA. Updated global burden of cholera in endemic countries. PLoS Negl Trop Dis. 2015. 9(6): e0003832.
[4] Clemens JD, Nair GB, Ahmed T, Qadri F, Holmgren J. Cholera. Lancet. 2017. 390(10101): 1539-1549.
[5][英]瑪麗•道布森,醫學圖文史,金城出版社 2016.
[6][英] 史蒂夫·帕克,DK醫學史,中信出版集團,2019.
[7] Sack DA. A new era in the history of cholera: the road to elimination. Int J Epidemiol. 2013. 42(6): 1537-40.
